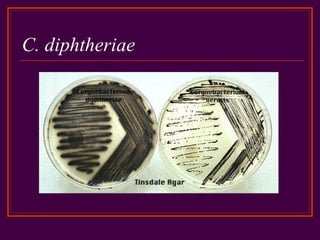
C. diphtheriae

El documento describe el género bacteriano Corynebacterium, incluyendo Corynebacterium diphtheriae que causa difteria. C. diphtheriae es un bacilo gram-positivo que produce una toxina potencialmente mortal si se ingiere o absorbe. La difteria es una enfermedad aguda que se caracteriza por la formación de una membrana pseudomembranosa en la garganta u otras membranas mucosas. El documento también discute el diagnóstico y control de la difteria a través de la vacunación y el trat